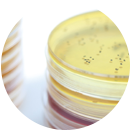

科技为真,经营为诚,服务为善——提供从益生菌种子到终端产品的全端解决方案
即食型益生菌制剂定制开发,丰富的菌株资源,支持多元化复配方案,满足客户差异化的应用需求,优化配方结构,控制产品成本。
至今已为1000+家客户持续提供优质产品与服务,益生菌制剂累计出货过百亿条。
针对不同人群,不同消费需求,开发并形成多样的产品配方,可满足多渠道、多层面的客户需求。
与多家三甲级医院建立临床合作,菌株功能适用性及安全性得到充分验证。
为不同发展阶段、不同需求的客户提供量身定制的产品配方、包装设计等服务。
专业研发团队技术支持、市场策划推广支持、严苛的质量管控体系,完善的售前、售中、售后全周期服务体系。

粉剂

液体

颗粒剂

片剂
 |
 |
 |
 |
 |
两歧双歧杆菌TMC3115 |
植物乳杆菌LP45 |
嗜酸乳杆菌La28 |
副干酪乳杆菌YMC1069 |
鼠李糖乳杆菌LR863 |
| 维护肠道菌群平衡,缓解便秘;抑制脂肪合成;调节血糖血脂代谢 | 有效抑制致病菌;缓解抗生素引起的肠道紊乱;缓解酒精性肝损伤。 | 增强人体免疫;抗过敏;缓解胃部不适 | 促进肠道消化吸收;缓解乳糖不耐;抗过敏 | 维护口腔生态平衡,抑制口腔致病菌 |
| 应用方向:益生菌粉、奶粉、酸奶、饮料、糖果 | 应用方向:益生菌粉、奶粉、酸奶、饮料、糖果 | 应用方向:益生菌粉、奶粉、酸奶、饮料、糖果 | 应用方向:益生菌粉、奶粉、酸奶、饮料、牙膏、糖果 | 应用方向:牙膏、糖果 |
儿童龋齿、中老年牙周炎、口气清新

缓解酒后腹泻、头晕、呕吐等不适症状,动物实验验证可以实现酒后护肝作用

便秘、腹泻、AAD腹泻、肿瘤腹泻

吸附烧烤类致癌物质苯并芘及重金属、铅和铬

降低IGE含量,缓解过敏症状

通过益生菌调节,抑制脂肪细胞的合成,减少脂肪堆积

增加AKK菌与短链脂肪酸,辅助缓解二型糖尿病

有效抑制阴道加德纳、白色念珠菌,维护女性生殖道健康

通过益生菌代谢产降压肽,通过降压肽实现调节血压效果

建立肿瘤免疫动物模型,筛选具有肿瘤免疫的益生菌

破坏脲酶活性,抑制幽门螺杆菌生长,阻断其在胃黏膜表面黏附,减少幽门螺杆菌对人体产生的危害

那曲4580代谢产生神经递质类物质,如GABA,色氨酸、乙酰胆碱等,缓解焦虑,改善睡眠

发掘市场应用需求

功能应用研究

配方/规格/产业化设计

产品包装设计

产品生产加工
技术、营销支持
